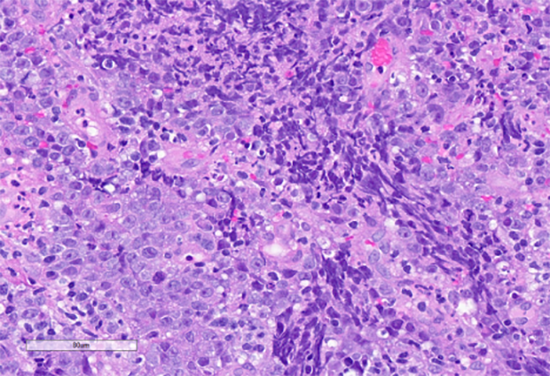

February 2025 Case
Clinical History
A 73-year-old patient with a history of gastroesophageal reflux disease and one month progression of dysphagia to solids and liquids underwent esophagogastroduodenoscopy for evaluation. Esophagogastroduodenoscopy revealed a large, bleeding, fungating, non-circumferential mass measuring 6.4 cm in the cardia, which was biopsied. The endoscopic, histologic, and key immunohistochemical features of the mass are demonstrated below.

Figure 1: Endoscopic appearance of the bleeding and fungating gastric cardia mass.

Figure 2: Low power view. Hematoxylin and eosin stain.
Figure 3: High power view. Hematoxylin and eosin stain. Highlights nests of atypical epithelioid cells and associated lymphoid cells.

A) SALL4

B) Pancytokeratin

C) SOX10

D) INI-1

E) Desmin

F) BRG1 (SMARCA4)

G) CD45

H) EBER
Figure 4: Immunohistochemical stains. A) Pancytokeratin (Oscar) is positive in atypical epithelioid cells. B) SOX10 is negative. C) Desmin is negative. D) SALL4 is negative. E) EBER (ISH) is negative. F) CD45 highlights background lymphoid cells. G) BRG1 (SMARCA4) shows loss of nuclear staining in atypical epithelioid cells. H) INI-1 (SMARCB1) is retained.
What is the most likely diagnosis?
A. Gastric carcinoma with lymphoid stroma (EBV-associated)
B. Diffuse large B-cell lymphoma (DLBCL)
C. Undifferentiated gastric carcinoma
D. Metastatic melanoma
E. Metastatic germ cell tumor
Correct answer:
C. Undifferentiated gastric carcinoma
Discussion
The histologic sections of the biopsied gastric cardia mass showed discohesive sheets of highly atypical cells with patchy areas of tumor necrosis. Scant residual background gastric cardia-type mucosa is identified. On high power the tumor cells are predominantly epithelioid and notable for prominent nucleoli, increased nuclear to cytoplasmic ratio, nuclear membrane irregularity and a marked increase in mitotic activity. A prominent lymphoid component, consisting predominantly of small lymphocytes, was interspersed between the atypical epithelioid cells. The tumor was poorly differentiated and based on histologic features alone, a definitive cell lineage could not be determined. A broad immunohistochemical (IHC) panel was required to determine the cell lineage with differentials including carcinoma, lymphoma, sarcoma, melanoma and germ cell tumors alike.
Epithelial membrane antigen (EMA) and pancytokeratins (Oscar & 8/18) were focally positive in the epithelioid tumor cells. CD3 and CD20 highlighted the background lymphocytes. The following IHC markers were negative in the tumor cells: CD45, SOX10, desmin, CD117, DOG-1, SALL4, synaptophysin, chromogranin and P40. EBER (in-situ) was negative. IHC for DNA mismatch repair (MMR) proteins showed intact expression. PD-L1 CPS score was <1. IHC for BRG1 (SMARCA4) and INI-1 (SMARCB1) were performed to examine components of the SWI/SNF chromatin-remodeling complex. INI-1 (SMARCB1) showed retained nuclear expression, however, complete loss of nuclear expression for BRG1 (SMARCA4) was identified. Subsequent genomic profiling showed copy number losses for SMARCA4 and 9p (CDKN2A/2B). TP53 and FBXW7 missense alterations were also identified. The overall findings were most compatible with the rarely described BRG1 (SMARCA4)-deficient undifferentiated gastric carcinoma.
The fifth edition of the World Health Organization (WHO) classification describes undifferentiated gastric carcinoma as a malignant epithelial tumor composed of anaplastic cells with no specific cytologic or architectural differentiation. These tumors are highly aggressive with poor patient outcomes. Among undifferentiated gastric carcinoma variants, rare reports have described inactivation of the SWI/SNF chromatin-remodeling complex, in particular proteins encoding SMARCB1, SMARCA2, SMARCA4, and ARID1A protein subunits. Inactivation of these proteins has been associated with variable rhabdoid features.
Inactivation of SMARCA4 (BRG1) has been identified as a driver molecular event in other malignancies including small cell carcinoma of the ovary hypercalcemic type, SMARCA4 deficient undifferentiated uterine sarcoma and SMARCA4 deficient thoracic tumors, among others. Although rare, loss of SMARCB1 has also been identified in highly aggressive undifferentiated carcinomas of the gastrointestinal tract, most commonly arising from the colon. These rare cases have also been associated with loss of the mismatch-repair (MMR) proteins in addition to microsatellite instability (MSI).
Being able to further classify undifferentiated gastric carcinoma with a SWI/SNF chromatin-remodeling complex deficiency can help guide patient management. Although there are currently no FDA approved indicated therapies, clinical trial opportunities are available for such patients. This case highlights the importance in poorly differentiated tumors that not only identifying cell lineage, but possible driver mutations play an important clinical role in patient management.
References
1. Agaimy A, Daum O, Märkl B, Lichtmannegger I, Michal M, Hartmann A. SWI/SNF Complex-deficient Undifferentiated/Rhabdoid Carcinomas of the Gastrointestinal Tract: A Series of 13 Cases Highlighting Mutually Exclusive Loss of SMARCA4 and SMARCA2 and Frequent Co-inactivation of SMARCB1 and SMARCA2. Am J Surg Pathol. 2016 Apr;40(4):544-53. doi: 10.1097/PAS.0000000000000554. PMID: 26551623.
2. Al-Shbool G, Krishnan Nair H. SMARCA4-Deficient Undifferentiated Tumor: A Rare Malignancy With Distinct Clinicopathological Characteristics. Cureus. 2022;14(10):e30708.
3. Lin Z, Li Q, He Y, Guo S, Ye Y, Liu Z. Case report: Gastric carcinoma with SMARCA4 deficient: two cases report and literature review. Front Oncol. 2024 Feb 6;14:1297140. doi: 10.3389/fonc.2024.1297140. PMID: 38380366; PMCID: PMC10878417.
4. Kolin DL, Dong F, Baltay M, Lindeman N, MacConaill L, Nucci MR, Crum CP, Howitt BE. SMARCA4-deficient undifferentiated uterine sarcoma (malignant rhabdoid tumor of the uterus): a clinicopathologic entity distinct from undifferentiated carcinoma. Mod Pathol. 2018 Sep;31(9):1442-1456. doi: 10.1038/s41379-018-0049-z. Epub 2018 Apr 26. PMID: 29700418.
5. Conlon N, Silva A, Guerra E, Jelinic P, Schlappe BA, Olvera N, Mueller JJ, Tornos C, Jungbluth AA, Young RH, Oliva E, Levine D, Soslow RA. Loss of SMARCA4 Expression Is Both Sensitive and Specific for the Diagnosis of Small Cell Carcinoma of Ovary, Hypercalcemic Type. Am J Surg Pathol. 2016 Mar;40(3):395-403. doi: 10.1097/PAS.0000000000000558. PMID: 26645725; PMCID: PMC4752399.
6. Russell-Goldman E, MacConaill L, Hanna J. Primary cutaneous SMARCA4-deficient undifferentiated malignant neoplasm: first two cases with clinicopathologic and molecular comparison to eight visceral counterparts. Mod Pathol. 2022 Dec;35(12):1821-1828. doi: 10.1038/s41379-022-01152-1. Epub 2022 Sep 9. PMID: 36085356.
7. Couto ME, Oliveira I, Domingues N, Viterbo L, Martins Â, Moreira I, Espírito-Santo A, Chacim S, Moreira C, Pereira D, Henrique R, Mariz J. Gastric Diffuse Large B-Cell Lymphoma: A Single-Center 9-Year Experience. Indian J Hematol Blood Transfus. 2021 Jul;37(3):492-496. doi: 10.1007/s12288-020-01391-9. Epub 2021 Jan 2. PMID: 33424149; PMCID: PMC7778395.
8. Mazumdar S, Sundaram S, Patil P, Mehta S, Ramadwar M. A rare case of metastatic germ cell tumor to stomach and duodenum masquerading as signet ring cell adenocarcinoma. Ann Transl Med. 2016 Aug;4(16):309. doi: 10.21037/atm.2016.08.20. PMID: 27668229; PMCID: PMC5009030.
9. WHO 5th Ed.